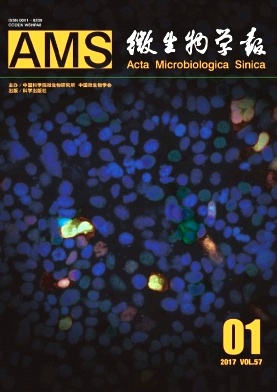
微生物学报

-
西安石油大学学报(自然科学版)
本刊是综合性学术刊物,是报道我院广大师生和研究人员及石油工业科技工作者科研成果的园地。学报的宗旨是:坚持党的四项基本原则,坚持社会主义办刊方向,认真执行党和国家颁布的有关科技出版物出版发行政策,及时向国内外介绍我院及石油工业在石油各专业及基础科学方面的最新研究成果、新信息及新方法,广泛开展...
- 主管单位:
- 主办单位:西安石油大学
- 出版地区:陕西省西安市
- 期刊级别:北大核心期刊
- 国内刊号:61-1435/TE
- 国际刊号:1673-064X
- 专业分类:学报期刊
- 邮发代号:不详
- 发行周期:双月
- 期刊收录:知网
人气:2439 -
武警后勤学院学报(医学版)
《武警后勤学院学报》(月刊)创刊于1992年,是由武警医学院主办、国内外公开发行的综合性医药卫生类学术期刊。主要报道基础医学、临床医学、预防医学、军事医学、药学和中国医学等领域的最新科研成果、新技术和新经验。设有专家论坛、述评、专题报道、论著、研究快报、综述、临床病理(病例)讨论、技术方法...
- 主管单位:武警后勤学院
- 主办单位:武警后勤学院
- 出版地区:天津市
- 期刊级别:统计源期刊
- 国内刊号:12-1429/R
- 国际刊号:2095-3720
- 专业分类:学报期刊
- 邮发代号:不详
- 发行周期:月刊
- 期刊收录:知网
人气:3193